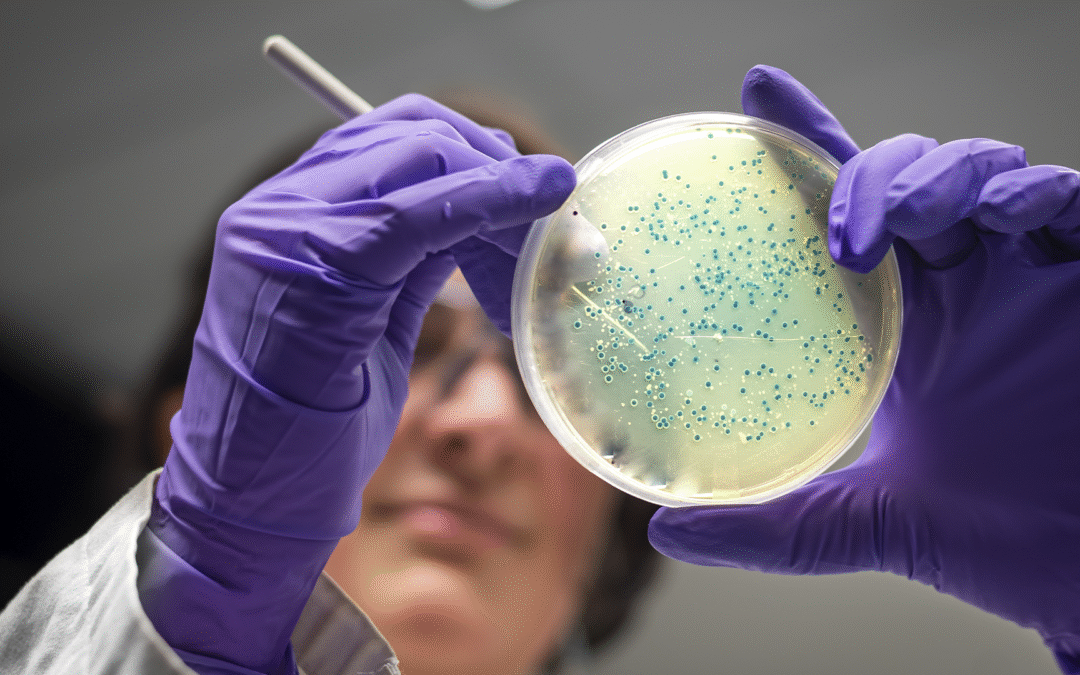
Hepatite B: Considerações Gerais e a Importância da Vacinação

Blog|Artigo

Vacinas e a Prevenção da Saúde: Investimento em Bem-Estar
A saúde é, sem dúvida, o nosso bem mais precioso. Manter-se saudável envolve diversos fatores, incluindo a adoção de hábitos de vida equilibrados, alimentação adequada, prática de exercícios e, fundamentalmente, a vacinação. A medicina tem avançado significativamente...

Sarampo e Rubéola: A Importância da Vacinação na Prevenção de Doenças
Nos últimos anos, foi promovida uma campanha nacional de vacinação voltada principalmente para adultos jovens, homens e mulheres de 20 a 39 anos. Essa iniciativa gerou dúvidas e até estranheza em algumas pessoas, que se questionaram: por que vacinar quem já foi...

Rotavírus: Vacinação na Prevenção de Gastroenterites Graves em Crianças
Atualmente, o rotavírus é considerado o principal agente causador de gastroenterites virais graves e de desidratação em lactentes e crianças em idade pré-escolar, tanto em países desenvolvidos quanto em nações em desenvolvimento. Como ocorre a transmissão?A...

Tudo o que você precisa saber sobre a Roséola Infantil
A Roséola Infantil, também conhecida como Exantema Súbito ou Pseudorrubeola, é uma infecção viral comum em crianças pequenas, especialmente entre 6 meses e 3 anos de idade. Causada pelo herpesvírus humano tipo 6 (HHV-6B) e, menos frequentemente, pelo HHV-7, a doença...

Eritema Infeccioso ou Quinta Moléstia
A Quinta Moléstia, conhecida como Eritema Infeccioso, é uma infecção viral comum especialmente entre crianças na fase escolar e pré-escolar. Apesar de muitas vezes ser considerada uma doença leve, é importante estar atento aos sintomas e às medidas de cuidado,...

O HPV e a Importância da Vacinação
O Papiloma Vírus Humano (HPV) é uma família de vírus composta por cerca de uma centena de diferentes subtipos, alguns dos quais podem causar doenças na pele e nas mucosas. Na maioria dos casos, essas infecções podem regredir de forma natural ou com tratamentos...

Obesidade Infantil e Juvenil: Prevenção e Cuidados para uma Vida Saudável
A saúde é um bem precioso que devemos preservar desde cedo. Manter-se saudável hoje faz parte de um esforço que está se tornando cada vez mais presente na nossa sociedade. Para as crianças e adolescentes, essa preocupação é ainda mais importante, pois eles estão em...

Meningites: Orientações Gerais e a Importância da Prevenção
A meningite é uma doença infecciosa grave que afeta crianças desde os primeiros meses de vida até adultos de todas as idades. Apesar de poder ocorrer em qualquer período do ano, sua incidência costuma aumentar durante as épocas mais frias. Quais são os sinais e...

Entendendo a Síndrome Mão-Pé-Boca: O Que os Pais Precisam Saber
Esta doença viral, embora geralmente leve, pode causar desconforto significativo para nossos pequenos pacientes. A SMPB é causada principalmente pelo vírus Coxsackie A16 e afeta principalmente crianças menores de 5 anos. Os sintomas característicos incluem febre,...
Hepatite B: Considerações Gerais e a Importância da Vacinação
A Hepatite B é uma infecção grave que afeta o fígado, representando um importante problema de saúde pública devido ao alto índice de morbidade e mortalidade em todo o mundo. O vírus causador é extremamente resistente às condições adversas do ambiente, podendo...
Fundado pelo Dr. Alberto Dabori, o Prevent se destaca por ser o primeiro centro especializado em vacinação da região, unindo tradição, inovação e um atendimento que prioriza o seu bem-estar.
Dr. Alberto Dabori
Contato e atendimento
Seg. a Sex., das 8h às 18h
Telefone
(16) 99758-4525 (16) 99758-3676
atendimento@preventvacinas.com.br
Endereço
Rua Bernardino de Campos, 1387 14015-130 – Ribeirão Preto – SP
Contato para imprensa
Seg. a Sex., das 9h às 18h
Telefone
(11) 99211-5097
advice@advice.com.br
Endereço
São Paulo – SP

